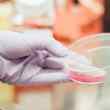
daeki, the chilean startup using saliva to diagnose diabetes

Contxto – As part of Start-Up Chile, The S Factory (TSF) recently shared its roster for its tenth generation of startups showcasing female tech entrepreneurship in its goods or services. Winners from this program will receive up to US$25,000, not to mention all-encompassing support to accelerate their projects.
As far as the participants go, TSF reviewed 210 applications before selecting the lucky 25 come from 12 countries. All of them incorporate female leadership, possess less than 12 months of development, and focus on some form of technology.
Each startup will receive around US$15,000, a one-year work visa, as well as four-month pre-acceleration programming.
The most qualified ones can even apply for visa extensions, in addition to the supplemental financial support of approximately US$7,000. If startups have a social or environmental impact, they can apply for yet another US$4,200.
About 28 percent of the participants are Chilean while the others are from elsewhere. By far, the most prominent industry represented within this batch is IT and Software. Health and Biotech come second followed by Retail, Wholesales and Consumer ventures.
Moreover, 40 percent are also in the process of pivoting their product among users and/or consumers. Only 28 percent currently have a functional product.
Without any further explanation, here’s the list of the frontrunners.
Probióticos en un Snack
Whether with pumpkin seed or chickpeas, this biotech startup adds probiotics to some of our favorite crunchy snacks. It uses a bio-agricultural scientific process known as “bioshelter” to achieve this.
ADD Shop
For consumers, ADD Shop combines social media networking as well as e-commerce into its modern solution. Users can apparently receive purchases at their homes within 90 minutes over the platform.
Nature AI
Like other TSF participants, this group utilizes AI to enhance medical care. Part of this involves discovering new drugs as well as treatment options via predictive technology. Hoping to work with pharmaceutical companies as well as patients, it bets on multi-drug therapy to provide an economic and scalable solution.
AprendeHoy
Bootcamps based on real challenges is how AprendeHoy promotes collaboration among users. Its SaaS platform is ideal for SMEs wanting to offer project-based learning opportunities to employees.
ARKIDZOO
Via augmented reality (AR), Arkidzoo develops tech products for pre-schoolers. This way, education is more effective not to mention more entertaining. Over time, the goal is to create a library of AR content.
Banquetéalo
Meaning “cater it” in Spanish, Banquetealo has innovatively simplified catering services. Within the platform, companies can easily connect to the best local catering services. All in one visit, users can find, schedule and pay online.
CanIEat Health
Not only backed by medical science but also data computer, this project assists clinicians in providing early-detection cancer services. Functioning within the biotech realm, it employs an algorithm that helps patients device nutritional plans as part of its anticancer treatment.
CaoPack
Imagine, packaging that’s completely biodegradable, compostable, and even soluble in water. Using scraps from the cocoa industry, this is a reality with CaoPack and its circular economy model where nothing goes to waste.
DrugLab
With DrugLab, users resort to its software and integrative tools to study drug development cycles. Within this comes data curation of preliminary knowledge, identification of druggable targets, modeling and simulation, plus much more.
Kubey Machine
At the core of Kubey Machine’s solution is the motivation to assist companies in developing self-manageable as well as customizable websites. It even helps partners integrate website data into applications as well as offers Augmented Reality features.
Life Drop
For women’s health, Life Drop has designed an intelligent pad capable of diagnosing vaginal infections. Specifically, the pad measures pH levels and changes color depending on the type of bacteria. This way, users can receive early diagnoses, but ultimately, attend to the matter promptly.
Minuta
There are more employment platforms, but this one is exclusively devoted to the restaurant industry. In other words, the SaaS allows establishments to find the most qualified employees via its API technology. When it comes to productivity, this solution could do wonders.
NeeKids
Leveraging AI, psycho-pedagogical, neurocognitive, in addition to neuropsychological tests for youngsters, are readily available over NeeKids. Resulting from the data, users can select the best hospital educational programs based on the needs of the child.
Ortherapy
Yet another medical solution within TSF, Ortherapy is a device that diminishes pain and slows down the development of diseases during rehabilitation. Being a wireless system, this service is practically available from almost anywhere.
Red_
Meaning network in Spanish, red is trying to connect half of the world to internet services. With this comes online education, jobs, financial services, plus so much more. Improved internet service will allow more people to pursue upward mobility opportunities.
Sami Beauty
Players in the Latin American beauty market can make better business decisions with Sami Beauty. Via AI technology, the platform analyzes user reviews about skincare and beauty products. This way, consumers can find the best item that fits their needs.
Seteasy
Believe it or not, but there is even a SaaS for movie and television industry professionals. Equipped with Seteasy’s platform, users can schedule crew schedules, manage budgets, create accounting documents, store photos, plus so much more.
Sextant
If you really miss Instagram’s geotag features, you can find it over Sextant. The travel app is an ideal way to plan trips or create customizable itineraries. Over the same app are also geo-tagging features, allowing users to categorize photos down to the very location. It also utilizes AI to provide tips and recommendations to users.
SmartLab
Navigate between videos and multimedia documents via SmartLab’s presentation software. Documents are organized into smart boxes, each categorized by color icons. Every box represents a different subject, them or category where uses can store relevant documents. In turn, these lead to other documents, which are known as trees over the platform.
Sharp Shark
Copyright infractions or intellectual property theft have the potential to be obsolete with Sharp Shark’s software. Specifically useful for journalists and photographers, the startup provides Blockchain technology for individuals to protect their authorship. Even better, everything is stored in an IPFS database with a timestamp.
Timplus
Students with learning disabilities use Timplus for educational programming using AI technology. Naturally, with playing comes valuable learning opportunities.
UnCart
To prevent the omnipresent danger of shopping cart abandonment, UnCart works with e-commerce merchants to provide them with the necessary retention tools. In the process, they can increase sales and customer conversions.
Valnux
Valnux turns industrial organic waste into fully-functioning kitchen utensils. Specifically, these products are made out of walnut shells, making items antibacterial and biodegradable. In turn, this prevents any foodborne disease and other public health concerns.
Wibo
This modular platform built to connect traditional retail with its modern consumer.
Winely
Many people adore wine. If you’re a major wine connoisseur, you can automate the wine sampling process over Winely. There’s even real-time data about winemakers ready to observe over the dashboard. Not only can winemakers save time and money but also energy with this platform.
The next applications for TSF11 will open on December 3, 2019.
-JA